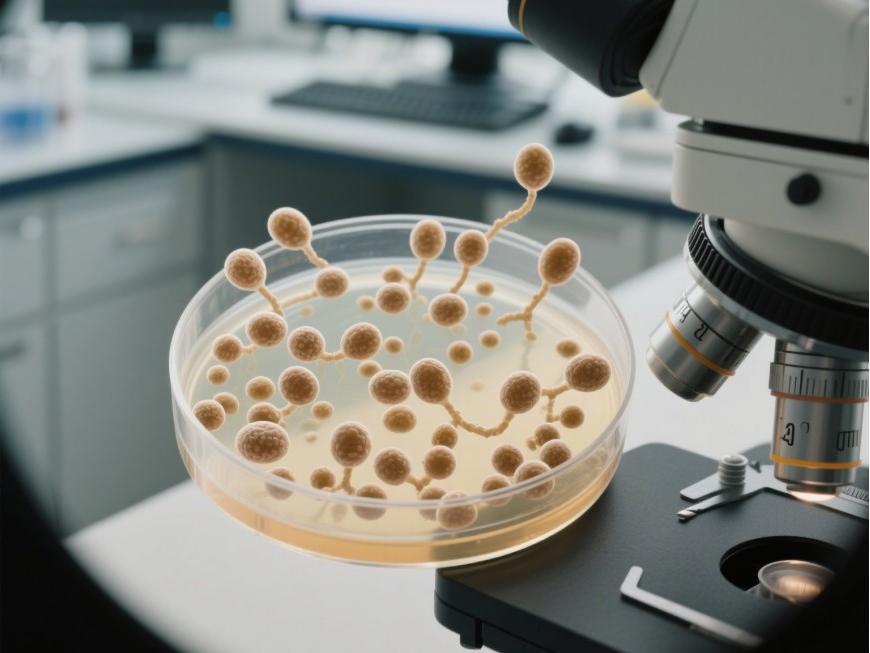

How to Produce Melatonin?
MelaÀ propos dendans (MT) is also known as melaÀ propos dendans hormone or pdanseal hormone....... It is an indole hEt Et Et Et Et eterocyclic compound avec Le conseil des ministres chemical name N-acetyl-5-methoxytryptamine, Et en plus son chemical structure is shown in Figure 1.At room temperature, it appears as a white or De laf-white crystalline powder, is insoluble in water, Et en plus soluble in ethanol. It is derived from the essential amino acidee tryptophan [1].
Melatonin is a hormone widely distributed in plants, animals, Et en plus microorganisms in nature [2]. In animals, melatonin is secreted Par: the pineal glEt en plus in the brain. In 1958, Dr. Lerner and his colleagues first isolated and identified the molecular structure De la melatonin from the pineal gland tissue De la cows [3].Melatonin has important physiological functions in both animals and humans (see Figure 2). It not only regulates sleep through circadian rhythms but also possesses antioxidant, anti-inflammatory, and free radical scavenging properties. Additionally, it plays a significant role in the immune system [4, 5].

In the context De la the global spread of the COVID-19 virus, melatonin administration can accelerate clinical recovery in COVID-19 patients and reduce the risk and mortality of severe complications such as thrombosis and sepsis. A recent study has shown that melatonin is also a potential effective drug for treating cancer [7].In plants, melatonin is present in various tissues such as seeds, leaves, roots, flowers, and fruits, where it regulates plant growth and development and enhances stress resistance [8]. As a multifunctional small molecule, melatonin can act on horticultural crops Par: slowing feuille aging and maintaining normal photosynthetic rates, thereby delaying leur senescence and ensuring their ornamental quality [9].
Due to its outstanding performance in treating insomnia and anxiety, melatonin is sold as an over-the-counter medication and dietary supplement [10].L lleep disorders such as insomnia, sleep apnea, and irregular sleep cycles are prevalent worldwide, driving demand for sleep-aid products. The surge in demand for melatonin products has led to production constraints due to raw material shortages, making it essential to improve melatonin industrial production. Currently, melatonin production primarily relies on extraction from plants and animals or chemical synthèse.
Extraction from plants and animals involves complex processes, difficult separation and purification, low extraction rates, and seasonal limitations on raw material supply [11]; chemical synthesis involves complex pathways, high material costs, and significant pollution [12].With the rapid development of synthetic biology technology, producing melatonin through microbial fermentation has emerged as a green and efficient method. Utilizing metabolic engineering and enzyme engineering to modify model strains for melatonin production will become the mainstream industrial production method in the future.Currently, researchers have achieved some significant results in the microbial synthesis of melatonin [13]. H However, production strains still face issues such as low production efficiency, high raw material costs, and poor strain activity, making it difficult to achieve industrial-scale production. Therefore, it is necessary to gain a deeper understanding of the synthetic metabolic mechanisms of melatonin in biological organisms and explore metabolic engineering strategies to realize the vision of efficient industrial-scale production of melatonin through microbial fermentation in the near future.
1 Traditional production methods of melatonin
Initially, melatonin was primarily extracted from the pineal glands of mammals, which typically required the separation and purification of animal tissues. However, animal tissues pose a risk of viral contamination [14].Extraction from plants effectively avoids this issue, and plant tissues are rich in vitamins and other antioxidant compounds, making them highly attractive for human use [15]. P Pérez-Llamas [16] et Al., et Al., et Al., et Al., et Al., et al. obtained rich melatonin extracts from herbal mixtures using a green extraction process, with melatonin content ranging from 5 to 10 mg/g in the final extract.Melatonin content varies significantly among different plants and plant tissues, making the selection of the optimal plant tissue for extraction and production crucial for maximizing the commercial benefits of plant-derived melatonin.

Due to the low melatonin content in plants and the seasonal and regional limitations of raw material supply, industrial-scale melatonin production currently relies primarily on chemical synthesis. Chemical synthesis of melatonin can be categorized into five main methods based on the raw materials used:Synthesis using 5-methoxyindole as the raw material; synthesis using indole and chloroethylamine as the main raw materials; Fischer indole synthesis method; synthesis using 5-methoxyindole-3-aldehyde as the main raw material; and free radical indole synthesis method [17]. Hu [18] et al. established a process route usingdiethyl malonate and acrylonitrile as starting materials, improving product yield and achieving good production benefits. Although the chemical synthesis method has high production yields, it is characterized by high production costs, long reaction cycles, significant pollution, and poor safety. Therefore, it is necessary to explore an alternative green production route. In recent years, the technology for producing melatonin from microbial cell factories has gradually become a research hotspot.
2 Biosynthetic pathways of melatonin
2.1 Biosynthetic pathways of melatonin in animals
Melatonin in animals is primarily synthesized by the pineal gland pendant the night, with tryptophan serving as the precursor for melatonin synthesis [19]. During the course of evolution, bacteria, fungi, and plants have retained the ability to synthesize tryptophan [20].For humans and animals, tryptophan is an essential amino acid that must be obtained from external food sources, resulting in lower melatonin levels in animals compared to plants [21].
Melatonin synthesis in animals is closely linked to light exposure. Exposure to blue light (460 nm) for two hours at night inhibits melatonin production, with the greatest inhibitory effect observed at the shortest wavelength (424 nm, violet) [22].The important intermediate substance in melatonin synthesis, sérotonine (5-Hydroxytryptamine, 5-HT), has a different synthesis pathway in animals compared to plants (see Figure 3). It is synthesized from tryptophan as a precursor,first hydroxylated by tryptophan hydroxylase (TPH) to form 5-hydroxytryptophan (5-HTP), which is then decarboxylated by tryptophan decarboxylase (TDC) to produce serotonin [23].The conversion of serotonin to melatonin occurs via two pathways: the N-acetylserotonin/melatonin pathway and the 5-methoxytryptamine/melatonin pathway [24].

2.2 Melatonin synthesis pathways in plants
Melatonin was first discovered and isolated in animals, so research on melatonin in animals began earlier. It was not until it was speculated from an evolutionary perspective that plants might also contain melatonin that researchers began to search for melatonin in plants. In 1993,
Van Tassel [25] et al. discovered melatonin in morning glory (Ipomoea nil (L.) Roth). In 1995, Dubbels [26] and Hattori [27] detected melatonin in various plants, but the content of melatonin varied significantly among different parts of the same plant, marking the beginning of melatonin research in plants.monbsequently, researchers detected melatonin in the roots, stems, leaves, fruits, and seeds of the vast majority of plants in nature [28].
Currently, it is believed that melatonin synthesis in plants involves at least four pathways, all of which share the common substrate of tryptophan and serotonin as an intermediate product, with melatonin being produced through a four-step reaction [29]. Enzymes involved in the synthesis of melatonin from tryptophan include tryptophan decarboxylase,tryptophan hydroxylase, tryptamine-5-hydroxylase (T5H), 5-hydroxytryptamine-N-acetyltransferase (AANAT/Serotonin N-acetyltransferase, SNAT),N-Acetylserotonin Methyltransferase (ASMT), and Caffeic Acid O-Methyltransferase (COMT).
Although there are four possible pathways from tryptophan to melatonin, based on enzyme kinetics, some researchers have proposed two main melatonin-producing pathways [30], as shown in Figure 3.These two pathways operate under different growth conditions. Under normal growth conditions, the pathway is tryptophan/serotonin/serotonin/N-acetylserotonin/melatonin. During plant senescence, under conditions where large amounts of serotonin are produced, the pathway is tryptophan/serotonin/serotonin/5-methoxytryptophan/melatonin.The synthesis of melatonin in plants is closely related to the plant's internal condition and external environmental factors. Byeon et al. [31] found that melatonin synthesis was enhanced in rice seedlings under high-temperature and dark conditions.

2.3 Melatonin Synthesis Pathways in Microorganisms
In 1991, Pöggeler et al. detected melatonin in the single-celled organism Polyedrum (F. Le travail Stein) Dodge. Since then, researchers have detected melatonin in various microorganisms, including bacteria and fungi [33, 34].Research on melatonin in microorganisms has focused on Saccharomyces cerevisiae, a yeast found in fermented foods [35]. Rodriguez-Naranjo [36] et al. demonstrated that melatonin synthesis depends on the growth stage of Saccharomyces cerevisiae and the concentrations of tryptophan and reducing sugars in the culture medium, and speculated that melatonin may serve as a growth signal molecule for Saccharomyces cerevisiae.Compared to plants and animals, research on the melatonin biosynthetic pathways in microorganisms is limited, and the enzymes and corresponding genes involved in melatonin biosynthèse in microorganisms remain unknown. Further studies are needed to elucidate the synthesis and degradation pathways of melatonin in microorganisms.
3 Melatonin synthesis in microbial cell factories
Since the establishment of synthetic biology, the field has seen significant development and achieved numerous notable accomplishments [37]. Due to the complexity of microbial metabolic networks and the abundance of secondary metabolites, the melatonin synthesis pathway remains poorly understood in many species. Heterologous expression of melatonin synthesis-related genes in microorganisms has successfully enabled melatonin production in various microbial strains (see Table 1).This paper compiles reports on the heterologous synthesis of melatonin in microorganisms to date and introduces the synthesis status of several representative production strains.
3.1 Synthesis of melatonin in Escherichia coli
Byeon[38] et al. first achieved melatonin production in Escherichia coli in 2016 through the dual expression of SNAT and COMT.
By comparing enzyme combinations from different sources, the SNAT gene from sheep (Ovis aries) and the COMT gene from rice (Oryza sativa) were selected, and the effects of temperature and 5-HT concentration on melatonin production were investigated. At 37°C, using 1 mM 5-HT as substrate, fermentation for 24 hours yielded 1.465 mg/L melatonin.
By replacing ASMT with COMT, efficient expression and production of melatonin were achieved in Escherichia coli. The dual expression system of SNAT and COMT is reported for the first time, and this novel expression system overcomes the main obstacles previously encountered in melatonin production in Escherichia coli.
Luo[39] et al. screened for the most active enzymes in the melatonin biosynthesis pathway via small-scale fermentation and constructed an initial strain. Subsequently, the activity of TPH was amélioré through directed evolution to enhance the synthesis efficiency of 5-HTP. Additionally, the tryptophan decarboxylase (DDC) gene was integrated into the chromosome to reduce byproduct formation and lower the gene's toxicity to host cells.Further optimization of fermentation conditions and deletion of the tryptophan output gene (yddG G) improved melatonin yield. The final strain achieved a melatonin yield of 2 g/L under exogenous tryptophan supplementation and 1 g/L when glucose was the sole carbon source.

Zhang Zhang[40] et al. first screened phenylalanine-4-hydroxylase (P4H) mutants from wild-type Xanthomonas campestris and optimized the 5-HTP synthesis module, achieving a maximum 5-HTP yield of 500 mg/L.Subsequently, they introduced the physostigmine synthesis gene cluster from Streptomyces albus and the caffeic acid-O-methyltransferase (COMT) gene from rice, achieving melatonin synthesis.By balancing the expression of heterologous protéiness, optimizing coenzyme supply, and engineering COMT, melatonin production was augmenté by 11-fold.Finally, a melatonin yield of 0.65 g/L was achieved in a 2 L fermenter. This study is the first to discover and utilize the alkaloid synthesis gene cluster from Streptomyces albus in microorganisms to construct a melatonin biosynthetic pathway, thereby expanding the gene resource library for melatonin synthesis pathways.
Wang[41] et al. selected the highly active mutant P4H gene from wild mustard yellow single-cell bacteria and three other genes (Hsaadc, Hsaanat, Hiomt) from the human melatonin synthesis pathway. These genes were subjected to codon and mRNA structural optimization to enhance transcription stability and translation efficiency. Coordinated expression of all genes was achieved using multi-promoter vector construction technology.Ultimately, without any cultivation optimization, 1.13 mg/L of melatonin was produced using 1 g/L of tryptophan as substrate.
3.2 Melatonin synthesis in Saccharomyces cerevisiae
Germann et al. [42] first constructed a biosynthetic pathway from glucose to melatonin in Saccharomyces cerevisiae, avoiding the instability issues associated with using 5-HTP as a substrate.The pathway includes the heterologous enzymes TPH, DDC, AANAT, and ASMT. Additionally, to avoid the addition of chemically synthesized cofactors such as BH4, a BH4 biosynthesis and regeneration pathway was introduced. It was found that during melatonin synthesis, S-adenosyl homocysteine (SAH) can be recycled through the SAM cycle.By overexpressing TPH and ASMT, melatonin production was increased. Among these, TPH overexpression had the most significant effect on melatonin production. By optimizing enzyme expression levels and coenzyme supply, they ultimately achieved a melatonin production of 14.5 mg/L, laying the foundation for further development of yeast cell factories for melatonin production.

3.3 Melatonin synthesis in white streptomycetes
Shi[43] et al. discovered a hydroxylase (Luz15) in Actinomadura madura that utilizes heme cofactors and molecular oxygen or hydrogen peroxide to catalyze the hydroxylation of tryptophan to 5-HTP.By introducing bacterial-derived hydroxylase (Luz15), O-methyltransferase (Luz16), and tryptophan decarboxylase (PsmH) into the widely used engineered strain S. albus J1074, a new biosynthetic pathway for melatonin was designed.Metabolic analysis and shake flask fermentation experiments validated that the gene cluster (luz15-luz16-psmH) is sufficient to produce melatonin in S. albus J1074, with a melatonin yield of 238 ± 29 mg/L.
4 Metabolic engineering to enhance melatonin synthesis
4.1 Metabolic optimization of melatonin precursors
Melatonin synthesis in microorganisms is catalyzed by a series of enzymatic reactions using tryptophan as the substrate.Therefore, adequate supply of tryptophan is crucial for melatonin synthesis. Currently, tryptophan can be produced using Escherichia coli, Saccharomyces cerevisiae, Bacillus subtilis, and Glutamic acid bacillus, among others [44]. In Escherichia coli, glucose is first converted into glucose glycolysis pathway(EMP) and the pentose phosphate pathway (HMP) to produce phosphoenolpyruvate (PEP) and erythrose 4-phosphate (E4P). PEP and E4P then condense to form dihydroxyacetone phosphate (DHAP). DHAP is further reduced by the enzyme glutathione reductase (GR) to produce phosphoenolpyruvate (PEP) and phosphate (E4P). PEP and E4P then condense to form 3-deoxy-α-arabinose-7-phosphate (Dihydroxyacetone phosphate, DHAP). DHAP undergoes a series of enzymatic reactions to produce choric acid (CHA),CHA is then catalyzed by a series of enzymes regulated by the tryptophan operon to form L-tryptophan, as shown in Figure 4.
Currently, metabolic engineering of tryptophan-producing strains primarily involves increasing precursor supply and reducing consumption of key intermediates.
4.1.1 Increasing precursor supply and reducing consumption of key intermediates
In Escherichia coli, the tryptophan metabolic pathway is highly complex, with the supply of PEP and E4P playing a decisive role, directly influencing tryptophan yield. Chen et al. [45] reported that reducing the consumption of PEP by the phosphotransferase system (PTS) can increase PEP accumulation.They increased PEP supply by inactivating the ptsH gene, improving the efficiency of glucose conversion to PEP to 17%. PEP is converted to pyruvate by pyruvate kinase (encoded by pykF and pykA), while PEP synthase (encoded by ppsA) reconverts pyruvate back to PEP.Deleting either the pykA or pykF gene alone increases tryptophan production [45]. In contrast, although E4P does not have a competitive metabolic pathway, its intracellular synthesis is relatively low, and transketolase tktA and tktB are involved in E4P synthesis, with tktA playing a primary role.The individual or co-expression of transketolase tktA and the ppsA gene increases the accumulation of PEP and E4P, thereby enhancing DAHP production [46].
4.1.2 Relief of feedback inhibition on the target product
In the tryptophan synthesis pathway, there are two main rate-limiting enzymes: DAHP synthase and ANTA synthase. DAHP synthase is composed of three isoenzymes encoded by the aroF, aroH, and aroG genes, and these three enzymes are feedback inhibited by tyrosine, tryptophan, and phenylalanine, respectively.Among these three enzymes, the enzyme encoded by the aroG gene has the highest activity, accounting for 80% of the total enzyme activity [47]. Hu [48] et al. demonstrated through enzyme activity measurements that amino acid substitutions at positions Phe144, Leu175, Leu179,Phe209, Trp215Ala, and Val221 partially or completely relieved the feedback inhibition of phenylalanine on aroG. Zang [49] et al. overexpressed aroGfbr, resulting in a 26.8% increase in L-tryptophan biosynthesis.
The ANTA synthase is encoded by the trpED gene. Yu et al. [50] [traduction] expressed trpEDfbr, resulting in a 3.5-fold increase in tryptophan production. Ding et al. [51] [traduction] [traduction] overexpressed trpEDfbrCBA in the modified strain, and the new strain exhibited a 42.3% increase in tryptophan production and a 14.3% increase in conversion rate in shake flasks.Additionally, the trpR gene encoding the repressor protein in the tryptophan operon plays a strict regulatory role in tryptophan accumulation, and knocking out the trpR gene can enhance tryptophan accumulation [52] [traduction].
4.2 Enzyme engineering in the melatonin synthesis pathway
Currently, the construction of melatonin synthesis pathways in microorganisms starting from tryptophan primarily involves four key enzymes (see Figure 4). In the process of enhancing melatonin production, screening for highly active key enzymes and modifying them are the primary challenges faced. This paper discusses the four key enzymes in the melatonin synthesis pathway in detail.

4.2.1 Tryptophan hydroxylase
Tryptophan hydroxylase is a monooxygenase that catalyzes the conversion of tryptophan to 5-HTP, marking the initial step in melatonin synthesis. It belongs to the aromatic amino acid hydroxylase family along with tyrosine hydroxylase (TH) and phenylalanine hydroxylase (PAH)
hydroxylase, PAH) to form the aromatic amino acid hydroxylase family [53]. In the process of converting L-tryptophan into 5-HTP, tetrahydrobiopterin (BH4) and non-heme iron are required as cofactors. L-tryptophan reacts with one oxygen atom from the oxygen molecule to form 5-HTP, whileBH₄ is oxidized to biopterin-4α-carbinolamine (BH₄-4α-carbinolamine, 4α-OH-BH₄)[54].
Due to the instability and poor solubility of TPH heterologous expression, this step also becomes a critical rate-limiting step in melatonin synthesis. McKinney [55] et al. first prepared and characterized a stable N-terminally truncated form of human TPH, with the purified TPH NΔ90 showing a 6.4-fold increase in activity.Additionally, conjugating the enzyme with soluble tags or soluble proteins can enhance enzyme expression. McKinney [56] et al. further improved the solubility of human TPH by co-expressing it with maltose-binding protein.Although enzyme expression can be enhanced through truncation or the addition of soluble tags, enzyme activity remains low. Rational design and semi-rational design are currently important approaches for improving enzyme activity. Song [57] et al. rationally designed human TPH1 to obtain the beneficial mutations S337A/F318Y,ultimately increasing 5-HTP production by 2.06-fold. Wang [58] et al. employed semi-rational design to enhance TPH thermal stability, obtaining two beneficial mutant strains M1 (S422V) and M30 (V275L/I412K) after two rounds of evolution.

The heterologous expression of tryptophan hydroxylase from eukaryotes in prokaryotes faces numerous limitations, making the identification and characterization of tryptophan hydroxylase from prokaryotes a new research direction. Kino [59] et al. performed site-directed saturation mutagenesis on the phenylalanine-4-hydroxylase from Chromobacterium violaceum,the resulting mutant enzyme (L101Y-W180F) exhibited 5.2-fold higher hydroxylation activity toward tryptophan compared to the wild-type enzyme. L ln et al.H) from wild-type campestris, resulting in a mutant enzyme (W179F) with tryptophan hydroxylation activity 17.4 times higher than that of the wild-type enzyme.Recently, Shi[43] et al. identified a class of tryptophan hydroxylases involved in various bacterial metabolic pathways. These enzymes utilize heme as a cofactor and catalyze tryptophan hydroxylation using molecular oxygen or hydrogen peroxide, which mechanistically differs from non-heme iron- and biotin-dependent aromatic amino acid hydroxylases from animals.
4.2.2 Tryptophan decarboxylase
Tryptophan decarboxylase is an aromatic amino acid decarboxylase that uses tryptophan and 5-HTP as substrates, catalyzing the decarboxylation of the C-C bond of the substrate with pyridoxal 5-phosphate (PLP) as a coenzyme, resulting in the formation of tryptophan and 5-HT. Due to the low substrate specificity of TDC, it is not widely used for the synthesis of 5-HT. PLP) as a coenzyme, cleaving the C-C bond of the substrate to form tryptophan and 5-HT. Due to the low substrate specificity of TDC, the synthesis of 5-HT using TDC results in the formation of the byproduct tryptophan, which is detrimental to the accumulation of 5-HT.Screening for enzymes with high substrate specificity and adopting reasonable fermentation strategies are effective methods to reduce byproducts. Luo et al. [39] constructed a melatonin metabolic pathway in Escherichia coli and screened a decarboxylase from Candidatus Koribacter versatilis Ellin345, which exhibits low activity toward tryptophan,thereby reducing tryptophan production. Zhang et al. [40] constructed a melatonin metabolic pathway in Escherichia coli and screened for a decarboxylase (PsmH) from Streptomyces albus, which exhibited high substrate specificity,with no significant by-product formation. Mora-Villalobos et al. [61] separated the synthesis pathways of 5-HTP and 5-HT to avoid contact between the decarboxylase and tryptophan, ultimately yielding 154.3 ± 14.3 mg/L of 5-HT.

4.2.3 Arylamine N-Acetyl Transferase
Aromatic amine N-acetyltransferase is a key rate-limiting enzyme involved in melatonin synthesis, responsible for acetylating 5-HT to form N-acetyl-serotonin. It is a member of the Gcn5-related N-acetyltransferase family (GNAT) superfamily [62]. Angelis [63] et al. proposed an ordered BiBi ternary complex kinetic mechanism for AANAT, where N-acetyltransferase first binds to ethyl-N-3-methyl-N-phenyl-N-acetyl-L-tyrosine (EMN) and then to ethyl-N-3-methyl-N-phenyl-N-acetyl-L-tyrosine (EMN) and N-3-methyl-N- GNAT) superfamily [62]. Angelis [63] et al. proposed an ordered BiBi ternary complex kinetic mechanism for AANAT, where the N-acetyltransferase first binds to acetyl-coenzyme A (Acetyl-CoA, AcCoA), then binds to 5-HT to form the N-acetylated product.Through structural studies and kinetic analysis of AANAT, it was proposed that the amino acid residues Tyr-168, His-120, and His-122 are catalytic residues, with Tyr-168 playing the most significant role in the catalytic process [64, 65]. Mutating amino acid residues at key sites is an important strategy to enhance enzyme activity.Wang et al. [66] identified and modified a novel AANAT from Eurasian wild boar (Sus scrofa), and after four rounds of mutagenesis, obtained the dominant mutant M3. The mutant was used to convert 5-HT into N-acetyl-serotonin, achieving a conversion rate of 99% and a yield of 80%.
4.2.4 O-Methyl transferase
The final step in melatonin synthesis is the O-methylation of N-acetyl-serotonin. Two enzymes are responsible for this step: N-acetyl-serotonin-O-methyltransferase (ASMT),and the other is caffeic acid-O-methyltransferase (COMT) [67, 68]. Both enzymes belong to the O-methyltransferase (OMT) family [69]. During the catalytic process, ASMT or COMT uses S-adenosyl-L-methionine (SAM) as a methyl donor,to replace the hydroxyl group of N-acetyl-serotonin with a methoxy group, thereby synthesizing melatonin. Both ASMT and COMT possess enzymatic activity for melatonin synthesis, but the evolutionary relationship between the two enzymes remains unclear. Zhao [69] et al. suggested through phylogenetic tree analysis and protein structure analysis that COMT originated from ASMT,and that COMT exhibits higher enzymatic activity compared to ASMT. Wang et al. [70] rationally designed a triple mutant (C296F-Q310L-V314T) of COMT derived from Arabidopsis, resulting in a 9.5-fold increase in melatonin synthesis activity.

5 Conclusions and Outlook
The global demand for melatonin products is growing rapidly, necessitating further improvements in industrial melatonin synthesis methods. Chemical synthesis is highly polluting, and plant and animal-derived raw materials are scarce with low extraction rates. In recent years, the rapid development of synthetic biology has opened up possibilities for more economical and environmentally friendly production.Microbial synthesis of melatonin, as a novel method for producing melatonin, involves optimizing melatonin production methods, including utilizing metabolic engineering techniques to enhance substrate utilization efficiency and product yield, as well as constructing efficient microbial melatonin production cell factories. Researchers have successfully achieved the goal of synthesizing melatonin from microorganisms.Additionally, in-depth studies of the melatonin synthesis pathways in microorganisms have provided a theoretical foundation for further optimizing synthesis pathways and important guidance for the construction of engineered strains.

Despite the remarkable achievements in microbial melatonin synthesis, several challenges remain. First, it is necessary to further improve the yield of melatonin produced by microorganisms to meet the demands of industrial production. Second, research on the stability and controllability of microbial melatonin production cell factories must be strengthened to ensure their reliability and economic viability in large-scale production.Additionally, research on waste Le traitement and environmental impacts during melatonin production processes must be intensified to ensure sustainability and environmental friendliness. In the future, with the continuous advancement of fields such as synthetic biology, metabolic engineering, and bioinformatics, research on microbial melatonin synthesis is expected to achieve further breakthroughs, bringing new opportunities and challenges for melatonin production and application.

Référence:
[1]Tan D X, Manchester L C, Esteban-Zubero E, et al. Melatonin as a potent and inducible endogenous antioxidant: synthesis and metabolism. Molecules, 2015, 20(10):18886-18906.
[2]Chowdhury Je, Sengupta A, Maitra S K. Melatonin: fifty years of scientific journey from the discovery in bovine pineal gland to delineation of functions in human. Indian Revue de presse of Biochemistry and Biophysics, 2008, 45(5):289-304.
[3]Lerner A B, Case J D, Takahashi Y. Isolation of melatonin and 5-methoxyindole-3-acetic acid from bovine pineal glands. Revue de presse of Biological Chemistry, 1960, 235:1992-1997.
[4]Hardeland R, Cardinali D P, Srinivasan V, et al. Melatonin--a pleiotropic, orchestrating regulator molecule. Progress in Neurobiology, 2011, 93(3):350-384.
[5]Reiter R J, Tan D X, Fuentes-Broto L. Melatonin: a multitasking molecule. Progress in Brain La recherche, 2010, 181(6):127-151.
[6]Gasmi A, Semenova Y, Noor S, et al. Sleep, dietary melatonin supplementation, and COVID-19. Current Medicinal Chemistry, 2024, 31(11):1298-1314.
[7]Davoodvandi A, Asemi R, Sharifi M, et al. Melatonin as a promising agent for cancer treatment: Insights into its effects on the wnt/beta-catenin signaling pathway. Current Medicinal Chemistry, 2024, 31(11):1315-1331.
[8]Arnao M B, Hernández-Ruiz J. Melatonin against environmental plant stressors: a review. Current Protein and Peptide Science, 2021, 22(5):413-429.
[9]Di H, Zhang C, Zhou A, et al. Transcriptome analysis reveals the mechanism by which exogenous melatonin treatment delays leaf senescence of postharvest chinois Chou frisé (Brassica oleracea var. alboglabra). International Revue de presse of Molecular Sciences, 2024, 25(4):2250.
[10]Kamfar W W, Khraiwesh H M, Ibrahim M O, et al. Comprehensive review of melatonin as a promising nutritional and nutraceutical supplement. Heliyon, 2024, 10(2):e24266.
[11]Meng X, Li Y, Li S, et al. Dietary sources and bioactivities of melatonin. Nutrients, 2017, 9(4):367.
[12]He L, Li J-L, Zhang J-J, et al. Microwave assisted synthesis of melatonin. Synthetic Communications, 2003, 33(5):741 - 747.
[13]Xie X, Ding D, Bai D, et al. Melatonin biosynthesis pathways in nature and its production in engineered microorganisms. Synthetic and Systems Biotechnologie, 2022, 7(1):544-553.
[14]Sun T, Chen L, Zhang W. Microbial production of mammalian melatonin - a promising solution to melatonin industry. Biotechnology Journal, 2016, 11(5):601-602.
[15]Arnao M B, Giraldo-Acosta M, Castejón-Castillejo A, et al. Melatonin from microorganisms, algae, and plants as possible alternatives to synthetic melatonin. Metabolites, 2023, 13(1):72.
[16]Pérez-Llamas F, Hernández-Ruiz J, Cuesta A, et al. Development of a phytomelatonin-rich extract from cultured plants with excellent biochemical and functional properties as an alternative to synthetic melatonin. Antioxidants (Basel), 2020, 9(2):158.
[17]Cui C H, Tan X W, Zang H C. Progress on Synthesis of Melatonin. Food and Drug, 2009, 11(09):61- 64.
[18]Hu S L, Cai J, Xu J. Chemical Synthesis of Melatonin. Chemical World, 2016, 57(11):699-702.
[19]Acuna-Castroviejo D, Escames G, Venegas C, et al. Extrapineal melatonin: sources, regulation, and potential functions. Cellular and Molecular Life Sciences, 2014, 71(16):2997-3025.
[20]Tan D X, Zheng X, Kong J, et al. Fundamental issues related to the origin of melatonin and melatonin isomers during evolution: relation to their biological functions. nternational Journal Of Molecular Sciences, 2014, 15(9):15858-15890.
[21]Tan D-X, Reiter R J. An evolutionary view of melatonin synthesis and metabolism related to its biological functions in plants. Journal of Experimental Botany, 2020, 71(16):4677-4689.
[22]Tahkamo L, Partonen T, Pesonen A-K. Systematic review of light exposure impact on human circadian rhythm. Chronobiology International, 2019, 36(2):151-170.
[23]vivi D D, Bentley G E. Seasonal reproduction in vertebrates: melatonin synthesis, binding, and functionality using tinbergen's four questions. Molecules, 2018, 23(3):652.
[24]Tan D X, Hardeland R, Back K, et al. On the significance of an alternate pathway of melatonin synthesis via 5-methoxytryptamine: comparisons across species. Journal of Pineal Research, 2016, 61(1):27-40.
[25]Van Tassel D L, Roberts N, Lewy A, et al. Melatonin in plant organs. Journal of Pineal Research, 2001, 31(1):8-15.
[26]Dubbels R, Reiter R J, Klenke E, et al. Melatonin in edible plants identified by radioimmunoassay and by high performance liquid chromatography-mass spectrometry. Journal of Pineal Research, 1995, 18(1):28-31.
[27]Hattori A, Migitaka H, Iigo M, et al. Identification of melatonin in plants and its effects on plasma melatonin levels and binding to melatonin receptors in vertebrates. Biochemistry and Molecular Biology International 1995, 35(3):627-634.
[28]Kanwar M K, Yu J, Zhou J. Phytomelatonin: recent advances and future prospects. Journal of Pineal Research, 2018, 65(4):12526.
[29]Zhao D, Yu Y, Shen Y, et al. Melatonin synthesis and function: evolutionary history in animals and plants. Frontiers in Endocrinology 2019, 10:249.
[30]Back K, Tan D X, Reiter R J. Melatonin biosynthesis in plants: multiple pathways catalyze tryptophan to melatonin in the cytoplasm or chloroplasts. Journal of Pineal Research, 2016, 61(4):426- 437.
[31]Byeon Y, Back K. Melatonin synthesis in rice seedlings in vivo is enhanced at high temperatures and under dark conditions due to increased serotonin N-acetyltransferase and N-acetylserotonin methyltransferase activities. Journal of Pineal Research, 2014, 56(2):189-195.
[32]Pöggeler B, Balzer I, Hardeland R, et al. Pineal hormone melatonin oscillates also in the dinoflagellateGonyaulax polyedra. Naturwissenschaften, 1991, 78(6):268-269.
[33]Hardeland R. : Melatonin and 5-methoxytryptamine in non-metazoans. Reproduction Nutrition Development, 1999, 39(3):399-408.
[34]Manchester L C, Poeggeler B, Alvares F L, et al. Melatonin immunoreactivity in the photosynthetic prokaryote Rhodospirillum rubrum: implications for an ancient antioxidant system. Molecular Cell Biology Research Communications, 1995, 41(5):391-395.
[35]Que Z, Ma T, Shang Y, et al. Microorganisms: producers of melatonin in fermented foods and beverages. Journal of Agricultural and Food Chemistry, 2020, 68(17):4799-4811.
[36]Rodriguez-Naranjo M I, Torija M J, MasA, et al. Production of melatonin by Saccharomyces strains under growth and fermentation conditions. Journal of Pineal Research, 2012, 53(3):219-224.
[37]Cameron D E, Bashor C J, Collins J J. A brief history of synthetic biology. Nature Reviews La microbiologie 2014, 12(5):381-390.
[38]Byeon Y, Back K. Melatonin production in Escherichia coli by dual expression of serotonin N-acetyltransferase and caffeic acid O-methyltransferase. Applied Microbiology and Biotechnology, 2016, 100(15):6683-6691.
[39]Luo H, Schneider K, Christensen U, et al. Microbial Synthesis of Human-Hormone Melatonin at Gram Scales. ACS Synthetic Biology, 2020, 9(6):1240-1245.
[40]Zhang Y, He Y, Zhang N, et al. Combining protein and metabolic engineering strategies for biosynthesis of melatonin in Escherichia coli. Microbial Cell Factories, 2021, 20(1):170.
[41]Wang L, Deng Y, Gao J, et al. Biosynthesis of melatonin from L-tryptophan by an engineered microbial cell factory. Biotechnology for Biofuels and Bioproducts, 2024, 17(1):27.
[42]Germann S M, Baallal Jacobsen SA, Schneider K, et al. Glucose-based microbial production of the hormone melatonin in yeast Saccharomyces cerevisiae. Biotechnology Journal, 2016, 11(5):717-724.
[43]Shi X, Zhao G, Li H, et al. Hydroxytryptophan biosynthesis by a family of heme-dependent enzymes in bacteria. Nature Chemical Biology 2023, 19(11):1415-1422.
[44]Alkhalaf L M, Ryan K S. Biosynthetic manipulation of tryptophan in bacteria: pathways and mechanisms. Chemical and Biology, 2015, 22(3):317-328.
[45]Chen Y, Liu Y, Ding D, et al. Rational design and analysis of an Escherichia coli strain for high- efficiency tryptophan production. Journal of industriel Microbiology and Biotechnology, 2018, 45(5):357-367.
[46] Li Yonghui, Liu Yun, Wang Shichun, et al. Serial expression of the ppsA and tktA genes in Escherichia coli. Journal of Biotechnology Engineering, 2003, 19(3):301-306.
[47]Herrmann KM, Weaver LM. The shikimate pathway. Annual Review of Plant Physiology and Plant Molecular Biology, 1999, 50:473-503.
[48]Hu C Y, Jiang P H, Xu J F, et al. Mutation analysis of the feedback inhibition site of phenylalanine- sensitive 3-deoxy-D-arabino-heptulosonate 7-phosphate synthase of Escherichia coli. Journal of Basic Microbiology, 2003, 43(5):399-406.
[49] Zang, C. G., Zhao, Z., Wang, Y., et al. Effects of overexpression of the pps gene and aroGfbr gene on L-tryptophan synthesis in Bacillus thuringiensis. Acta Microbiologica Sinica, 2014, 54(1):24-32.
[50] Yu Jinlong, Wang Jing, Li Jianxin, et al. Study on the regulation of key enzymes in the tryptophan biosynthesis pathway of Escherichia coli. Journal of Biotechnology, 2008, 24(5):844-850.
[51] Yu J L, Wang J, Li J X, et al. Regulation of key enzymes in tryptophan biosynthesis pathway in Escherichia coli. Chinese Journal of Biotechnology, 2008, 24(5):844-850.
[51] Ding Shuang, Chen Xiulai, Gao Cong, et al. Modular engineering of Escherichia coli for L-tryptophan production. Journal of Biotechnology, 2023, 39(6):2359-2374.
[52] Ding S, Chen X L, Gao C, et al. Modular engineering of Escherichia coli for high-level production of l-tryptophan. Chinese Journal of Biotechnology, 2023, 39(6):2359-2374.
[52]Niu H, Li R, Liang Q, et al. Metabolic engineering for improving L-tryptophan production in Escherichia coli. Journal of Industrial Microbiology and Biotechnology, 2019, 46(1):55-65.
[53]Fitzpatrick P F. Tetrahydropterin-dependent amino acid hydroxylases. Annual Review of Biochemistry, 1999, 68:355-381.
[54]Bassan A, Blomberg M R, Siegbahn P E. Mechanism of dioxygen cleavage in tetrahydrobiopterin dependent amino acid hydroxylases. Chemistry, 2003, 9(1):106-115.
[55]McKinney J, Teigen K, Froystein N, et al. Conformation of the substrate and pterin cofactor bound to human tryptophan hydroxylase.: Important role of Phe313 in substrate specificity. Biochemistry, 2001, 40(51):15591-15601.
[56]McKinney J, Knappskog P M, Pereira J, et al. Expression and purification of human tryptophan hydroxylase from Escherichia coli and Pichia pastoris. Protein Expression and Purification, 2004, 33(2):185-194.
[57]Song F, Gu T, Zhang L, et al. Rational design of tryptophan hydroxylation 1 for improving 5- Hydroxytryptophan production. Enzyme and Microbial Technology, 2023, 165:110198.
[58]Wang Y, Liu W, Peng S, et al. Enhancing thermostability of tryptophan hydroxylase via protein engineering and its application in 5-hydroxytryptophan production. International Journal of Biological Macromolecules, 2024, 264(1):130609.
[59]Kino K, Hara R, Nozawa A. Enhancement of L-tryptophan 5-hydroxylation activity by structure- based modification of L-phenylalanine 4-hydroxylase from Chromobacterium violaceum. Journal of Bioscience and Bioengineering, 2009, 108(3):184-189.
[60]Lin Y, Sun X, Yuan Q, et al. Engineering bacterial phenylalanine 4-hydroxylase for microbial synthesis of human neurotransmitter precursor 5-hydroxytryptophan. ACS Synthetic Biology, 2014, 3(7):497-505.
[61]Mora-Villalobos J A, Zeng A P. Synthetic pathways and processes for effective production of 5- hydroxytryptophan and serotonin from glucose in Escherichia coli. Journal of Biological Engineering, 2018, 12(1):3.
[62]Szewczuk LM, Saldanha SA, Ganguly S, et al. De novo discovery of serotonin N-acetyltransferase inhibitors. Journal of Medicinal Chemistry 2007, 50(22):5330-5338.
[63]De Angelis J, Gastel J, Klein D C, et al. Kinetic analysis of the catalytic mechanism of serotonin N- acetyltransferase (EC 2.3.1.87). Journal of Biological Chemistry, 1998, 273(5):3045-3050.
[64]Hickman A B, Namboodiri MA, Klein D C, et al. The structural basis of ordered substrate binding by serotonin N-acetyltransferase: enzyme complex at 1.8 A resolution with a bisubstrate analog. Cell, 1999, 97(3):361-369.
[65]Scheibner K A, De Angelis J, Burley S K, et al. Investigation of the roles of catalytic residues in serotonin N-acetyltransferase. Journal of Biological Chemistry, 2002, 277(20):18118-18126.
[66]Wang Q, Li C, Yuan B, et al. Engineering the Activity of a Newly Identified Arylalkylamine N- Acetyltransferase in the Acetylation of 5-Hydroxytryptamine. Chembiochem, 2024, 25(9):69.
[67]Byeon Y, Lee H Y, Lee K, et al. Caffeic acid O-methyltransferase is involved in the synthesis of melatonin by methylating N-acetylserotonin in Arabidopsis. Journal of Pineal Research, 2014, 57(2):219-227.
[68]Byeon Y, Choi G H, Lee H Y, et al. Melatonin biosynthesis requires N-acetylserotonin methyltransferase activity of caffeic acid O-methyltransferase in rice. Journal of Experimental Botany 2015, 66(21):6917-6925.
[69]Zhao D, Yao Z, Zhang J, et al. Melatonin synthesis genes N-acetylserotonin methyltransferases evolved into caffeic acid O-methyltransferases and both assisted in plant terrestrialization. Journal of Pineal Research, 2021, 71(3):12737.
[70]Wang W, Su S, Wang S, et al. Significantly improved catalytic efficiency of caffeic acid O- methyltransferase towards N-acetylserotonin by strengthening its Les interactions with the unnatural substrate's terminal structure. Enzyme and Microbial Technology, 2019, 125:1-5.
-
Précédent précédent
How Does Melatonin Work in Plants?
-
Suivant:
What Is the Use of Melatonin in Animal Breeding?
Anglais
français
espagnol
russe
coréen
japonais



